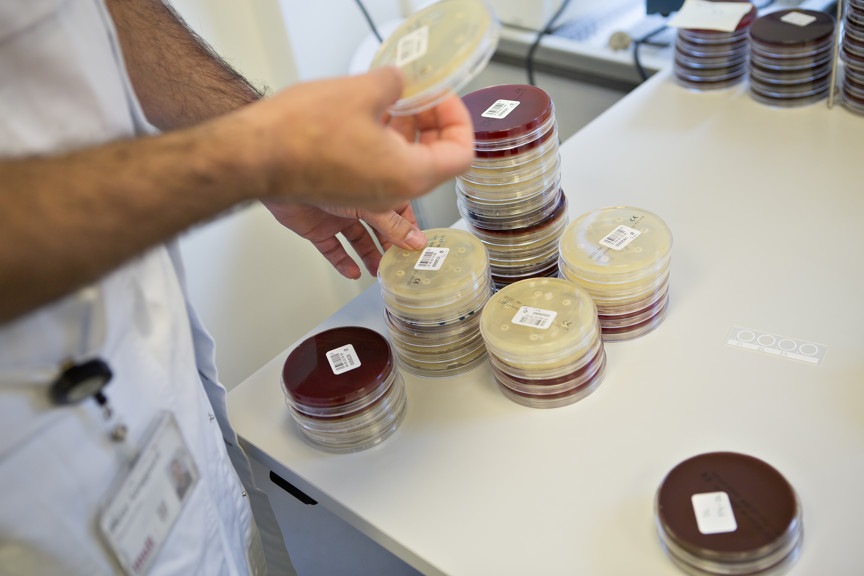

INFORMED

Kort om INFORMED
Hvordan bruges evidensbaserede forskningsresultater i politikudformning på sundhedsområdet –og hvad er virkningen af disse politikker? Det er de centrale spørgsmål i INFORMED-projektet.
Projektet fokuserer overordnet på tre områder:
Projektet er tværfagligt og inkluderer både økonomiske, sociologiske, og organisationsetnografiske analyser.
Se pdf med præsentationer fra eftermiddagsmødet om forskningens plads i politikudviklingen i sundhedsvæsenet her.
De står bag
En lang rækker personer har bidraget til at realisere INFORMED-projektet.
Projektleder og -deltager
Projektdeltagere
- Jakob Kjellberg, professor, VIVE
- Sarah Wadmann, seniorforsker, VIVE
- Amalie Martinus Hauge, seniorforsker, VIVE
- Mickael Bech, professor, VIVE
- Anna Kollerup Iversen, ph.d.-studerende, VIVE & Københavns Universitet (nu Medicinrådet)
- Nis Lydiksen, Ph.d.-studerende, VIVE & Syddansk Universitet (nu Socialstyrelsen)
- Søren Rud Kristensen, sundhedsøkonom, Syddansk Universitet
- Tim Doran, Professor of Health Policy, University of York
- Matt Sutton, Professor of Health Economics, University of Manchester
Advisory board
- Tor Iversen, professor, Oslo Universitet
- Stefan Timmermans, professor, University of California, Los Angeles
- Søren Brostrøm, Direktør, Sundhedsstyrelsen
Projektet er finansieret af Novo Nordisk Fonden.
Kliniske retningslinjer
I perioden 2012-2017 blev 47 nye nationale kliniske retningslinjer indført i Danmark. Hensigten med retningslinjerne var bl.a. at reducere variationen i klinisk praksis ved at indføre guidelines for, under hvilke omstændigheder en given behandling kunne vælges, fravælges eller begrænses.
I sagens natur er kliniske retningslinjer ikke obligatoriske anvisninger, men netop retningslinjer. Forskningen viser dog, at der i klinisk praksis er stærke incitamenter for at følge dem, bl.a. fordi de giver dokumenteret støtte til en given behandlingsbeslutning, og fordi de yder værn mod erstatningssager.
Perspektiver
Projektet peger overordnet på, at
- det er vigtigt at overveje, om omkostninger til udvikling og implementering af nye retningslinjer står mål med de mulige gevinster – og at sikre let mulighed for opfølgning
- der er en tendens til, at borgere med længere uddannelse i højere grad får den behandling, som de kliniske retningslinjer foreskriver
- designet af retningslinjer kan have betydning for retningslinjernes effektivitet og potentiale for at reducere ulighed i adgang til sundhedsydelser.
Tvivlsom effekt
Trods en investering på 80 millioner i udarbejdelsen af retningslinjerne var deres effekt på den kliniske praksis tvivlsom, viser INFORMED-projektet.
For det første medførte en lav evidensstyrke mange svage anbefalinger i de nationale kliniske retningslinjer. Dette skete i overensstemmelse med den valgte metode GRADE (Grading of Recommendations Assessment, Development and Evaluation), der er et internationalt brugt system til at vurdere kvaliteten af evidens og til at give anbefalinger. Er evidensen lav, bliver anbefalingen tilsvarende svag med klinisk uklarhed til følge.
For det andet blev der ikke etableret en samlet overvågning eller evaluering af den ændring i behandlingspraksis, som de nationale kliniske retningslinjer førte med sig. Og for det tredje blev der ikke taget hensyn til omkostningseffektivitet i implementeringen af retningslinjerne.
Projektet viser her vigtigheden af at overveje, om omkostninger til udvikling og implementering af nye retningslinjer står mål med de mulige gevinster – og at sikre let mulighed for opfølgning.
Case: Nationale kliniske retningslinjer om alkoholbehandling
De kliniske retningslinjer om behandling af alkoholafhængighed blev indført i 2015 og havde til formål at “højne og ensrette kvaliteten af alkoholbehandling i Danmark”. De rummede anbefalinger til både terapeutisk og farmakologisk behandling. INFORMED-projektet har undersøgt effekterne af sidstnævnte med særligt fokus på forskelle i effekt for forskellige aktører.
Projektet viser, at både behandlingscentre og almen praksis ændrede udskrivningspraksis efter indføring af retningslinjerne: Blandt medicinsk behandlede patienter steg brugen af nye lægemidler med ca. 10 procentpoint.
Ændringerne havde imidlertid ingen eller meget begrænset effekt på borgernes behandling og levevilkår i øvrigt. Der var dog en tendens til forskelle i effekten for borgere med forskellig uddannelsesbaggrund: For højtuddannede borgere sås en tendens til, at de i højere grad end kortuddannede borgere modtog den behandling, som de kliniske retningslinjer foreskriver.
Case: Kliniske retningslinjer om fosterdiagnostik

Fostervandsprøver blandt mødre med hh. sundhedsfaglig og ikke-sundhedsfaglig uddannelse
Hvilken betydning har patienters sundhedsfaglige viden for deres behandling i sundhedsvæsnet? INFORMED-projektet har undersøgt, hvordan retningslinjerne har påvirket lighed i adgang til fosterdiagnostik for gravide med forskellig faglig ekspertise på sundhedsområdet.
Projektet viser, at mødre med sundhedsfaglig baggrund, i perioden fra 1996 til 2004 i højere grad fik foretaget fostervandsprøve under aldersgrænsen end andre mødre (se figur). På dette tidspunkt lå beslutningen om henvisning til fostervandsprøve hos almen læge. Her havde mødre under 35 år, som havde en sundhedsfaglig uddannelse, 10 procentpoints større sandsynlighed for at få foretaget en fostervandsprøve end andre mødre, til trods for at det ikke lå indenfor rammerne af den aldersbaserede retningslinje.
Denne forskel forsvandt med indførslen af nye retningslinjer i 2018, der bl.a. flyttede beslutning om henvisning til fostervandsprøve fra almen læge til hospital. Resultaterne tyder på, at sundhedsfaglig viden kan påvirke den behandling man får i sundhedsvæsnet – og at kliniske guidelines, der rationerer adgang til behandling, kan reducere ulighed i adgang til sundhedsydelser, hvis forhandlingen om behandlingen er placeret det rette sted.
Case: Retningslinjer mod pludselig uventet spædbarnsdød
Sundhedsstyrelsen ændrede i 1998 sin vejledning om forebyggelse af pludselig spædbarnsdød (vuggedød), så man nu anbefalede, at spædbørn sov på ryggen. I projektet undersøges effekten af ændringer i retningslinjer, som var baseret på høj evidensstyrke, men som var umiddelbart svære at implementere.
Projektet viser, at organisering af sundhedsplejen var afgørende for implementeringen af den nye viden og retningslinjerne, og dermed den konkrete adfærdsændring hos nye forældre. Indføring af nye retningslinjer havde desuden en særlig gavnlig effekt blandt børn med det dårligste helbred, og blandt forældre med de laveste uddannelser og indvandrerbaggrund.
Artikler
- Lydiksen N, Greve J, Jakobsen M, Kristensen S. 2021. Using national clinical guidelines to reduce practice variation - the case of Denmark. Health policy (Amsterdam, Netherlands), 125 (6), pp. 793 - 798
- Westergaard, C. L., Doran, T., Greve, J., Kristensen, S. The impact of clinical guidelines adherence and patient outcomes—an evaluation of evidence-based guidelines on alcohol use disorder treatments across provider and patient groups. Submitted
- Greve, J, Lydiksen, N., Kristensen, S. Patient and Peer: Dual Agency and Rationing in Health Care. Submitted
- Altindag, O., Greve, J., Tekin, E. (forthcoming 2022) . Public Health Policy At Scale: Impact of a Government-sponsered Information Campaign on Infant Mortality in Denmark. Review of Economics and Statistics
Se Søren Rud Kristensens oplæg om kliniske retningslinjer fra eftermiddagsmødet herunder
Effekten af kliniske retningslinjer
Prioritering af ny medicin
Den demografiske udvikling, nye teknologiske muligheder og stigende forventninger til behandling skaber et stigende behov for prioriteringer i sundhedsvæsnet. Både på det politisk-administrative niveau og i den daglige kliniske praksis.
Fra Medicinrådet til klinisk praksis
Den demografiske udvikling, nye teknologiske muligheder og stigende forventninger til behandling skaber et stigende behov for prioriteringer i sundhedsvæsnet. Både på det politisk-administrative niveau og i den daglige kliniske praksis.
På lægemiddelområdet er der de senere år kommet en række nye typer lægemidler, som skaber håb om mere målrettet og præcis behandling af patienter. Eksempelvis er der markedsført nye former for immunterapi til behandling af kræft og genterapier til behandling af sjældne arvelige sygdomme.
Udviklingen skaber håb om at kunne bremse udviklingen af alvorlig sygdom, men med de mange nye muligheder følger også dilemmaer. Eksempelvis markedsføres nogle af de nye genterapier med en listepris på op til 14-20 mio. kr. pr. behandling. INFORMED-projektet har undersøgt de udfordringer, der kan opstå i det praktiske arbejde med at prioritere ny medicin i Medicinrådet og omsætte anbefalingerne i klinisk praksis.
Perspektiver
Projektet viser, at det i arbejdet med medicinprioritering er vigtigt at:
- skabe grundlag for at inddrage synspunkter fra berørte parter
- stræbe mod faglig konsensus og stå på mål for økonomiske prioriteringer
- anerkende, at prioritering også handler om at afslutte behandlinger.
Inddragelse af synspunkter
I Medicinrådet er der en høj grad af direkte interessentinddragelse, men INFORMED-projektet viser, at lige muligheder ikke altid er nok til at skabe lige vilkår for deltagelse. En del af patientrepræsentanterne har svært ved at deltage i de faglige drøftelser i fagudvalgene. Det skyldes især at den viden, som patientrepræsentanterne bliver bedt om at bidrage med – deres sygdoms- og behandlingserfaringer – ikke tæller som gyldig viden i de metodehåndbøger, som Medicinrådet arbejder efter.
Projektet peger på en række muligheder for at udvikle den eksisterende inddragelsesmodel: For det første det vigtigt at anerkende det grundlæggende skisma om, hvad der tæller som gyldig viden, og at afstemme forventningerne til patienternes bidrag. For det andet kan man give mulighed for at synliggøre mindretalssynspunkter i fagudvalgsrapporter. Og endelig kan rammerne for inddragende mødeledelse styrkes i fagudvalgene.
Faglig konsensus mellem beslutningstagere og klinikere
INFORMED-projektet viser, at klinikere udtrykker støtte til fælles, økonomisk informerede nationale retningslinjer for brug af ny medicin. Men de kan blive sat i vanskelige situationer, hvis der ikke opnås faglig konsensus om behandlingsanbefalinger, eller hvis politiske og administrative beslutningstagere ikke er klar til at stå på mål for økonomiske prioriteringer.
Noget af det som kan udfordre implementeringen af nationale anbefalinger, er hvis klinikernes relation til patienter og pårørende sættes under pres. Eksempelvis kan der opstå mistillid, hvis patienter og pårørende ikke kan gennemskue, om et nej til behandling skyldes kliniske eller økonomiske hensyn.
Prioritering handler også om at afslutte behandling
I den offentlige debat om prioritering er der meget fokus på, hvem der kan få adgang til nye behandlinger. Prioritering handler imidlertid også om, hvordan man får afsluttet behandling. Her viser INFORMED-projektet, at der er væsentlige forskelle blandt danske hospitaler på, hvornår og hvordan behandling for lungekræft bliver afsluttet. Dette har implikationer for patienternes sidste tid og brugen af ressourcer i sundhedsvæsenet.
Projektet peger på en række forhold, der kan understøtte beslutninger om behandlingsstop: For det første gode rammer og anledning til at udveksle behandlings- og afslutningsbeslutninger i lægegruppen, og opmærksomhed på at inddrage sygeplejerskers observationer. For det andet den rette frekvens for konsultationer – jo sjældnere man ser patienten, jo sværere er det at fange en forværring af helbredet. Og for det tredje, at der findes gode og tilgængelige alternative tilbud til patienten, når behandlingen afsluttes. Her kan der være en frygt for at slippe patienten til et tilbud, der er ukvalificeret eller ikke modsvarer patientens behov.
Artikler
- Steffensen, M.B., Matzen, C.L. & Wadmann, S. 2022. Patient participation in priority setting: Co-existing participant roles, Social Science & Medicine, 294: 114713,
- Wadmann, S., Hauge, A.M. & Navne, L.E. Good conduct in a context of rationing. A case study of how frontline professionals deal with distributive dilemmas of novel gene therapies, Sociology of Health & Illness (R&R)
- Hauge, A.M. (forthcoming) Diagnostic stratification – Molecular and economic configurations of lung cancer care. Sociology of Health and Illness
- Hauge, A.M. (2020). One last round of chemo? Insights from conversations between oncologists and lung cancer patients about prognosis and treatment decisions. Social Science & Medicine, 266, 113413.
- Hauge, A.M & Lydiksen, N. Can we organize to curb overtreatment? Management lessons from a study of Danish hospitals’ use of cancer treatment close to patients’ death. Nordic Journal of Health Economics (submitted)
Se Sarah Wadmann og Amalie Martinus Hauges oplæg "Prioritering af ny medicin – fra Medicinråd til klinisk praksis" herunder
Prioritering af ny medicin – fra Medicinråd til klinisk praksis
Specialeplanlægning
Op gennem 00’erne blev der investeret kraftigt i centralisering i sundhedsvæsenet, hvor mindre sygehuse eller sygehusafdelinger blev lukket, og nye, større specialiserede sygehuse etableret. Det skete bl.a. med baggrund i undersøgelser, som viste en sammenhæng mellem store sygehuse og høj kvalitet i behandlingen.
Kontaktperson: Jakob Kjellbjerg
INFORMED-projektet undersøger effekterne af specialiseringen gennem to casestudier:
- Effekten af at halvere af antallet af brystkræftafdelinger over en tiårig periode og
- Sikrer specialisering og kliniske retningslinjer ensartet behandling for øjensygdommen våd AMD? Derudover undersøges det, hvad der har drevet udgifterne, siden specialiseringen tog fart.
Perspektiver
Projektet peger overordnet på, at
- specialiseret behandling, der kræver erfaring eller opkvalificering bør overvåges og evt. centraliseres for at undgå lav kvalitet i behandlingen
- hvis behandlingen er simpel, er decentralisering effektivt til at sænke ventetider, sikre korrekt behandlingsinterval mv.
- det er nødvendigt at være opmærksomme på udgiftstrykket fra ældre kronikere: kan mængden af lægemidler og sundhedsydelser reduceres og/eller effektiviseres?
Case: Specialeplanlægning af brystkræftbehandling
I perioden mellem 2000 og 2011 blev antallet af afdelinger, der udfører operation for brystkræft, halveret.
Baseret på data fra forskellige danske registre viser projektet, at andelen af brystbevarende operationer er steget med knap 10 procentpoint som følge af centraliseringen. Udviklingen er drevet af, at de lukkede afdelinger udførte få brystbevarende operationer.
Den gennemsnitlige indlæggelsestid er også faldet fra 5 dage til godt 4 dage (et fald på 1,2 dag), mens der ikke er målbare effekter på reoperationer, ambulant behandling, brug af opioider eller patienternes dødelighed.
Der er ingen evidens for, at kvaliteten af brystkræftbehandlingen på de tilbageværende afdelinger er styrket yderligere af at de store afdelinger er blevet endnu større.
Case: Ny behandling af øjensygdommen våd AMD
I 2007 blev der introduceret en ny behandling til øjensygdommen våd AMD, den såkaldte anti-VEGF-terapi. Det skete med en national klinisk retningslinje og specialisering på få sygehusafdelinger i tre regioner.
Den nye behandling har bevirket, at langt færre patienter i dag bliver blinde eller svagtseende pga. sygdommen – men INFORMED-projektet viser, at der var stor forskel på regionernes implementering, både når det gjaldt selve behandlingen, dens effekt og dens økonomi. Regionen med de laveste omkostninger pr. patient havde de dårligste behandlingsresultater, men regionen med de højest omkostninger havde ikke de bedste behandlingsresultater. På tværs af regionerne var der store udfordringer med kapacitetsbegrænsninger og personalemangel.
Den region, der opnåede de bedste behandlingsresultater, var kendetegnet ved tre forhold: For det første foretog man en tidlig og vedvarende udbygning af kapaciteten, som betød at man var parat til det store indryk af patienter, der ønskede behandlingen. For det andet foretog man en tidlig og øget uddelegering af opgaver fra speciallæger til specialuddannede sygeplejersker, både når det gjaldt vurdering og udførelse af behandling. Og for det tredje samlede man helt konkret diagnostikken og behandlingsopstarten i et besøg og sparede dermed tid og ressourcer.
INFORMED-projektet viser her, specialisering og kliniske retningslinjer ikke nødvendigvis sikrer ensartet behandling på tværs af landet, hvis der er store kapacitetsbegrænsninger. Det er essentielt, at de udpegede sygehusafdelinger er organisatorisk parate til at tage imod en stor patientgruppe, der venter på den nye behandling.
Hvad driver sundhedsydelserne?
INFORMED-projektet undersøger også, hvilke faktorer der driver sundhedsydelserne i perioden fra 2006 til 2018, hvor specialiseringerne fandt sted.
Projektet finder her, at udgiften er steget hurtigere for den enkelte ældre end den enkelte yngre patient, sådan at den aldersfordelte udgiftskurve er blevet stejlere (se figur). Den enkelte ældre patient er altså blevet dyrere for sundhedsvæsenet, men der er stor forskel på sygdomsgrupper: For ældre med hjertekar - og kræftsygdomme er kurven ikke blevet stejlere, mens den for ældre med kroniske sygdomme er blevet stejlere.

Udgifter til sundhedsydelser for forskellige aldersgrupper
Artikler
- Kollerup, A. Worth the trip? The effect of hospital clinic closures for patients undergoing scheduled surgery. Social Science & Medicine, forthcoming 2022.
- Iversen, A.K.; Wadmann, S., Bek, T. & Kjellberg, J. National clinical guidelines and treatment centralization do not guarantee consistency in health care delivery. A mixed-method study of wet Age-Related Macular Degeneration treatment in Denmark, Health Policy (in press)
- Kollerup, A., Kjellberg, J. & Ibsen, R. 2022. Ageing and health care expenditures: the importance of age per se, steepening of the individual-level expenditure curve, and the role of morbidity. Eur J Health Econ.
Se Anna Kollerup Iversens oplæg "Effekten af specialeplanlægningen" herunder
Effekten af specialeplanlægningen
Paneldebat
Paneldebat om forskningens plads i udviklingen af sundhedsvæsenet.
Hvad skal der til, hvis politikudvikling skal være drevet af evidens, og er det reelt noget, der efterspørges? Panelet består af
- Direktør Søren Brostrøm, Sundhedsstyrelsen
- Afdelingschef Søren Gaard, Sundhedsministeriet
- Professor Jakob Kjellberg, VIVE
- Professor Tor Iversen, Oslo Universitet
- Moderator: Sundhedspolitisk analytiker og journalist ved Altinget Ole Toft